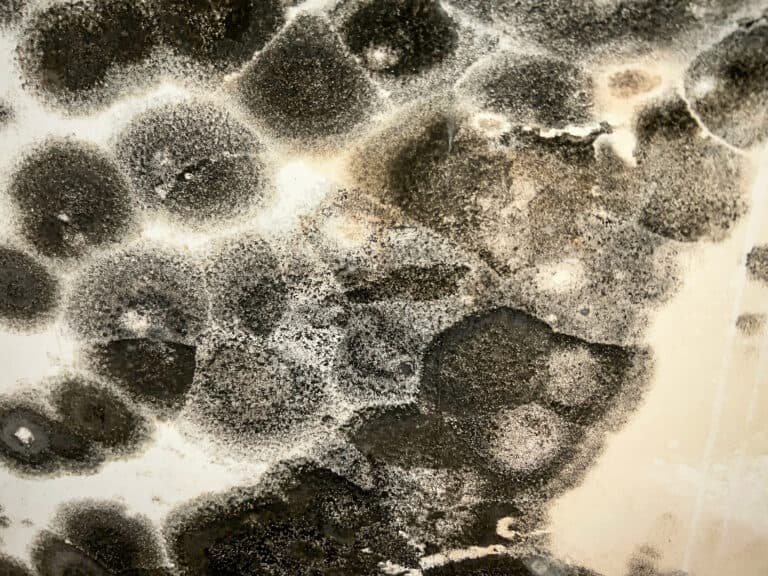
Black mold growth on surface, hazardous environmental concern, mold remediation, mold removal experts.

Schafer is your Environmental Consulting Services Solution
We service the greater Denver area, all of Colorado, and western states. Schafer has performed projects in Rochester, New York and in Antarctica and McMurdo Station. We will provide services wherever requested.
Serving all of Colorado, including Denver, Boulder, Colorado Springs, Pueblo and the Western Slope
Navigating environmental health and safety regulations can be complex, but finding the right solution shouldn’t be. Schafer offers a calm, methodical approach to identifying and managing environmental risk. We provide the accurate data and expert guidance you need to protect your project liabilities and move your project forward with confidence.
Schafer has an excellent record of success working with Colorado companies and governmental agencies, municipalities, and institutions. As a result, we are adept and versatile in managing large, multi-site projects on a task-order basis, and working with Colorado regulators, including the CDPHE, on our clients’ behalf.
All asbestos, lead based paint, and hazardous material projects conducted by Schafer have strictly adhered to OSHA, EPA, and CDPHE regulations, from inception to completion.
Our expert staff has successfully managed thousands of projects from multi-million dollar commercial and industrial to small scale residential. For each project, we provide practical solutions for environmental problems. There have been no regulatory violations, negative legal actions or lost time injuries on any of the projects that Schafer has managed. We strive to stay on schedule and control costs while maintaining regulatory compliance and environmental health and safety.
-
Asbestos
Schafer provides end-to-end asbestos consulting—from inspections and sampling to abatement oversight and demolition permit support—ensuring projects remain compliant, efficient, and protected at every stage.
-
Lead
Schafer delivers CDPHE-certified lead inspections, risk assessments, and remediation planning to help property owners and project teams meet regulatory requirements with confidence and clarity.
-
Mold
Schafer conducts thorough mold and moisture investigations to identify contamination, determine scope, and guide effective remediation—protecting indoor air quality and occupant health.
-
Soil Sampling and Remediation
Schafer provides comprehensive soil sampling and remediation services, offering practical strategies and full project oversight to address contamination and meet regulatory standards.
-
Waste Characterization
Schafer evaluates waste streams for environmental and regulatory compliance, helping clients properly classify, handle, recycle, or dispose of materials generated during construction, demolition, and remediation projects.
-
Environmental Site Assessment
Schafer performs Phase I and Phase II Environmental Site Assessments to identify potential environmental risks, support due diligence, and inform redevelopment or property transactions.
-
Meth
Schafer is a CDPHE-certified methamphetamine consulting firm that assesses, documents, and verifies cleanup of meth-affected properties to ensure safe reoccupation and regulatory compliance.
-
Radon
Schafer provides certified residential and commercial radon testing, delivering clear results and guidance to help clients understand risks and next steps.
-
Mercury
Schafer oversees mercury remediation projects—particularly in mercury-containing gymnasium floors—providing monitoring, documentation, and clearance verification to ensure safe removal and compliance.
-
Water Sampling
Schafer offers water quality sampling and environmental consultation to identify potential contaminants and help clients understand, manage, and respond to water-related health and regulatory concerns.
-
Stormwater Management
Schafer provides comprehensive stormwater management services, including permitting support, planning, inspections, and compliance oversight to help clients meet state and federal requirements with confidence. From SWMP development to construction-phase support and reporting, Schafer ensures stormwater systems are effective, documented, and regulatory-ready.
-
Indoor Air Quality
Schafer provides Indoor Air Quality assessments for a wide variety of indoor air contaminants and pollutants, such as Volatile Organic Compounds. We can perform an overall assessment to determine if “sick building syndrome” is occurring within a building.
Services We Provide
Our Certified Staff Includes
Asbestos Building Inspectors
Air Monitoring Specialists
Asbestos Project Designers
Experienced Mold Inspectors
Lead Paint Inspectors

Lead Risk Assessors
OSHA HAZWOPERs
Management Planners
Radon Measurement Professionals
Qualified Stormwater Inspectors
Methamphetamine Affected-Property Consultants
Ready to Get Started?
At Schafer Environmental, we bring over two decades of hands-on environmental consulting and industrial hygiene expertise to every project we undertake. Based in Lakewood with experience throughout Colorado and beyond, our team provides thoughtful, science-driven solutions — from asbestos, lead, and mold sampling to project design, regulatory reporting, and oversight — all tailored to your unique needs. We’re intentionally the kind of firm that balances the technical depth and resources of a larger team with the responsiveness, care, and dedication that only a tight-knit group can deliver. When you work with us, you’re partnering with specialists who know the rules, stay ahead of changing regulations, and keep your project compliant, safe, and on track.